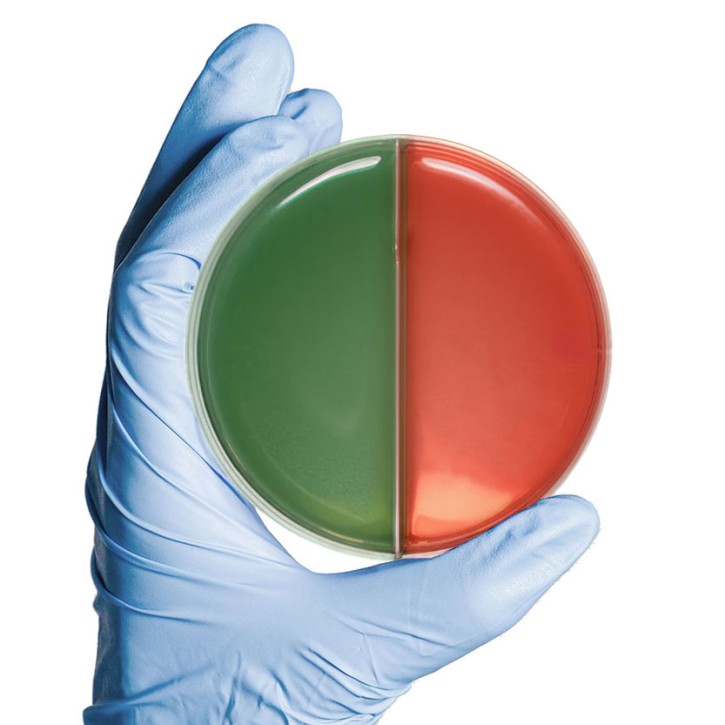

Produktbeschreibung
- 20 Platten à 90 mm
- EAN: 30382902575628
nicht als Reinheitskultur gemäß RiliBÄK geeignet. Hierfür empfehlen wir eine CLED-Platte (MD2475) in Kombination mit der McConkey/BlutCNA-biplate (MD2893).
Downloads
GBA (0.05 MB)
GBA MD2891
Folgende Produkte könnten Sie auch interessieren
Impfösen 10µl - (50x 20 Stk., sterilisiert) blau, aus PE
Impfschlingen oder Impfösen gehören zur Standardausstattung jedes...
EUR 34,00 - EUR 39,00
zzgl. 19 % USt ggf. zzgl. Versandkosten
Gram-IDent (10ml KOH wässrige Lsg. pH 13,5) zur Unterscheidung Gram+ und Gram- Bakterien
Gram-IDent dient zur einfachen, bestätigenden Unterscheidung zwischen...
EUR 6,50
zzgl. 19 % USt ggf. zzgl. Versandkosten
MICRONAUT MCN Software UR EUCAST 13.0-konform
MICRONAUT-UR Software: - Eindeutige Patienten ID (Import oder freie Eingabe) -...
EUR 2.800,00
zzgl. 19 % USt ggf. zzgl. Versandkosten
Die MICRONAUT-UR Platten dienen der Identifizierung (54 Taxa) und...
EUR 595,00
zzgl. 19 % USt ggf. zzgl. Versandkosten
Heratherm IGS60 Brutschrank (75L)
Kleiner, moderner Brutschrank für das ärztliche Labor mit 75L Nutzraum und...
EUR 1.699,00
zzgl. 19 % USt ggf. zzgl. Versandkosten
EUR 26,00 - EUR 32,00
zzgl. 19 % USt ggf. zzgl. Versandkosten
Antibiotika 6er-Ring HWI-S3 (50 Stk.) EAU Leitlinie HWI First line
Antibiotikaring 2 - HWI-S3 Mit dem 6er-Antibiotika-Ring MD2417 haben wir auf...
EUR 37,00 - EUR 44,00
zzgl. 19 % USt ggf. zzgl. Versandkosten
MacConkey/Columbia-CNA biplate Agar - 20 Stk.
MacConkey II Agar ist ein selektives Differenzierungsmedium zur Isolierung und...
EUR 13,98 - EUR 14,50
zzgl. 19 % USt ggf. zzgl. Versandkosten
Katalase bezeichnet ein Enzym, das Wasserstoffperoxid (H2O2) zu Sauerstoff (O) und...
EUR 7,50 - EUR 9,50
zzgl. 19 % USt ggf. zzgl. Versandkosten
Oxidase-Teststreifen - 100 Stk.
Der Oxidase-Test dient der weiteren Unterscheidung von als gram-negativ,...
EUR 22,00 - EUR 27,00
zzgl. 19 % USt ggf. zzgl. Versandkosten
Mueller-Hinton-II Agar fertig - 20 Stk.
Der Müller-Hinton-Agar (MH-Agar) ist ein nicht-synthetisches, sparsames,...
EUR 8,68
zzgl. 19 % USt ggf. zzgl. Versandkosten
Columbia-Schafsblut-CNA-Agar II - 20 Stk.
Der Blut-CNA Agar oder korrekterweise Columbia-CNA-Agar mit 5% Schafsblut ist...
EUR 8,50 - EUR 8,90
zzgl. 19 % USt ggf. zzgl. Versandkosten
U11Plus Harnteststreifen (150 Stck) für DocUReader 2 PRO und LabUReader Plus 2
LabStrip U11 Plus ist ein hochwertiger, nicht-blutender Urinteststreifen....
EUR 14,00 - EUR 19,50
zzgl. 19 % USt ggf. zzgl. Versandkosten
tetra-staph - 10 Stk. - kleine bunte Reihe für Staphylokokken
Der tetra-staph ist eine kleine bunte Reihe zurverlässlichen Differenzierung der...
EUR 16,50 - EUR 19,50
zzgl. 19 % USt ggf. zzgl. Versandkosten
Küvetten für UriSed mini (600 Stck) URS-9961-1 für UriSed mini Automaten
UriSed-Küvetten sind Einwegbehälter aus Polycarbonat zur Analyse...
Preis auf Anfrage
zzgl. 19 % USt ggf. zzgl. Versandkosten
Kunden kauften auch
Ampicillin AMP 10 µg (1x 50 Bl., BD) EUCAST 14.0-konform
HINTERGRUND Antibiotika-Testblättchen werden zur Bestimmung der semiquantitativen...
EUR 5,36 - EUR 5,50
zzgl. 19 % USt ggf. zzgl. Versandkosten
4-Kammer-Reservoirs (Einweg, 350 Stck) für Inokkulat. (2+2+2+2) von 96w-Microtiter plates
Die 4-Kanal-Reservoirs dienen der symmetrischen, einfachen Beimpfung von...
EUR 125,00
zzgl. 19 % USt ggf. zzgl. Versandkosten
Ampicillin AMP 10 µg (1x 50 Bl., Mast) EUCAST 14.0-konform
Hintergrund: Antibiotika-Testblättchen werden zur Bestimmung der...
EUR 5,46 - EUR 5,50
zzgl. 19 % USt ggf. zzgl. Versandkosten
Cefotaxim CTA 5 µg (5x 50 Bl., Oxoid) EUCAST 14.0-konform
HINTERGRUND Antibiotika-Testblättchen werden zur Bestimmung der semiquantitativen...
EUR 37,50
zzgl. 19 % USt ggf. zzgl. Versandkosten
Columbia-Schafsblut-CNA-Agar II - 120 Stk.
Der Blut-CNA Agar oder korrekterweise Columbia-CNA-Agar mit 5% Schafsblut ist ein...
EUR 52,08
zzgl. 19 % USt ggf. zzgl. Versandkosten
Kontakt
Bei Rückfragen erreichen Sie unser Kundenbüro telefonisch unter +49 201 21961-701 werktags von 8:00-12:00 und 13:00-17:00 Uhr.
Alternativ schicken Sie uns ein Fax an +49 2573 69795-9917 oder eine E-Mail an service@aurosan.de
Vielen Dank, Ihr Team von AUROSAN.
AUROSAN GmbH | Frankenstr. 231, D-45134 Essen | Tel. +49 201 21961-701 | Fax +49 2573 69795-9917
service@aurosan.de | www.aurosan.de | www.aurosan-shop.de | www.aurosan-gesundes-leben.de